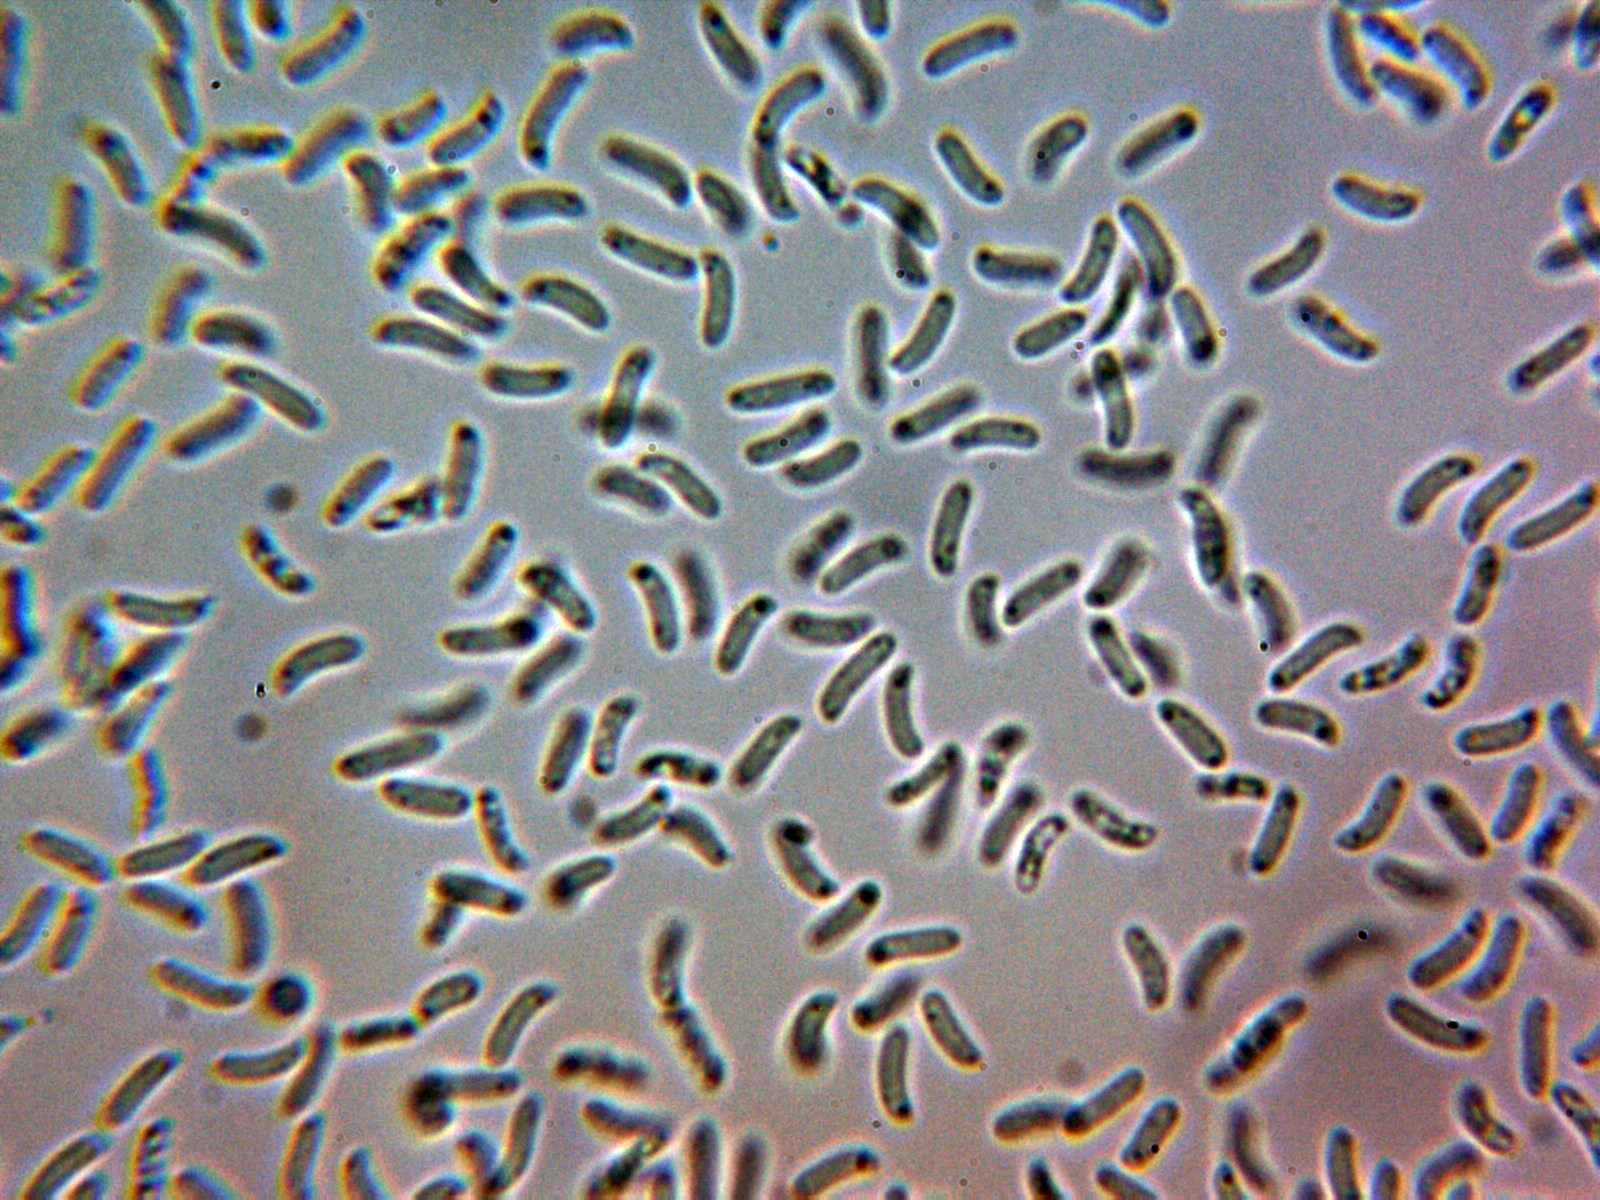
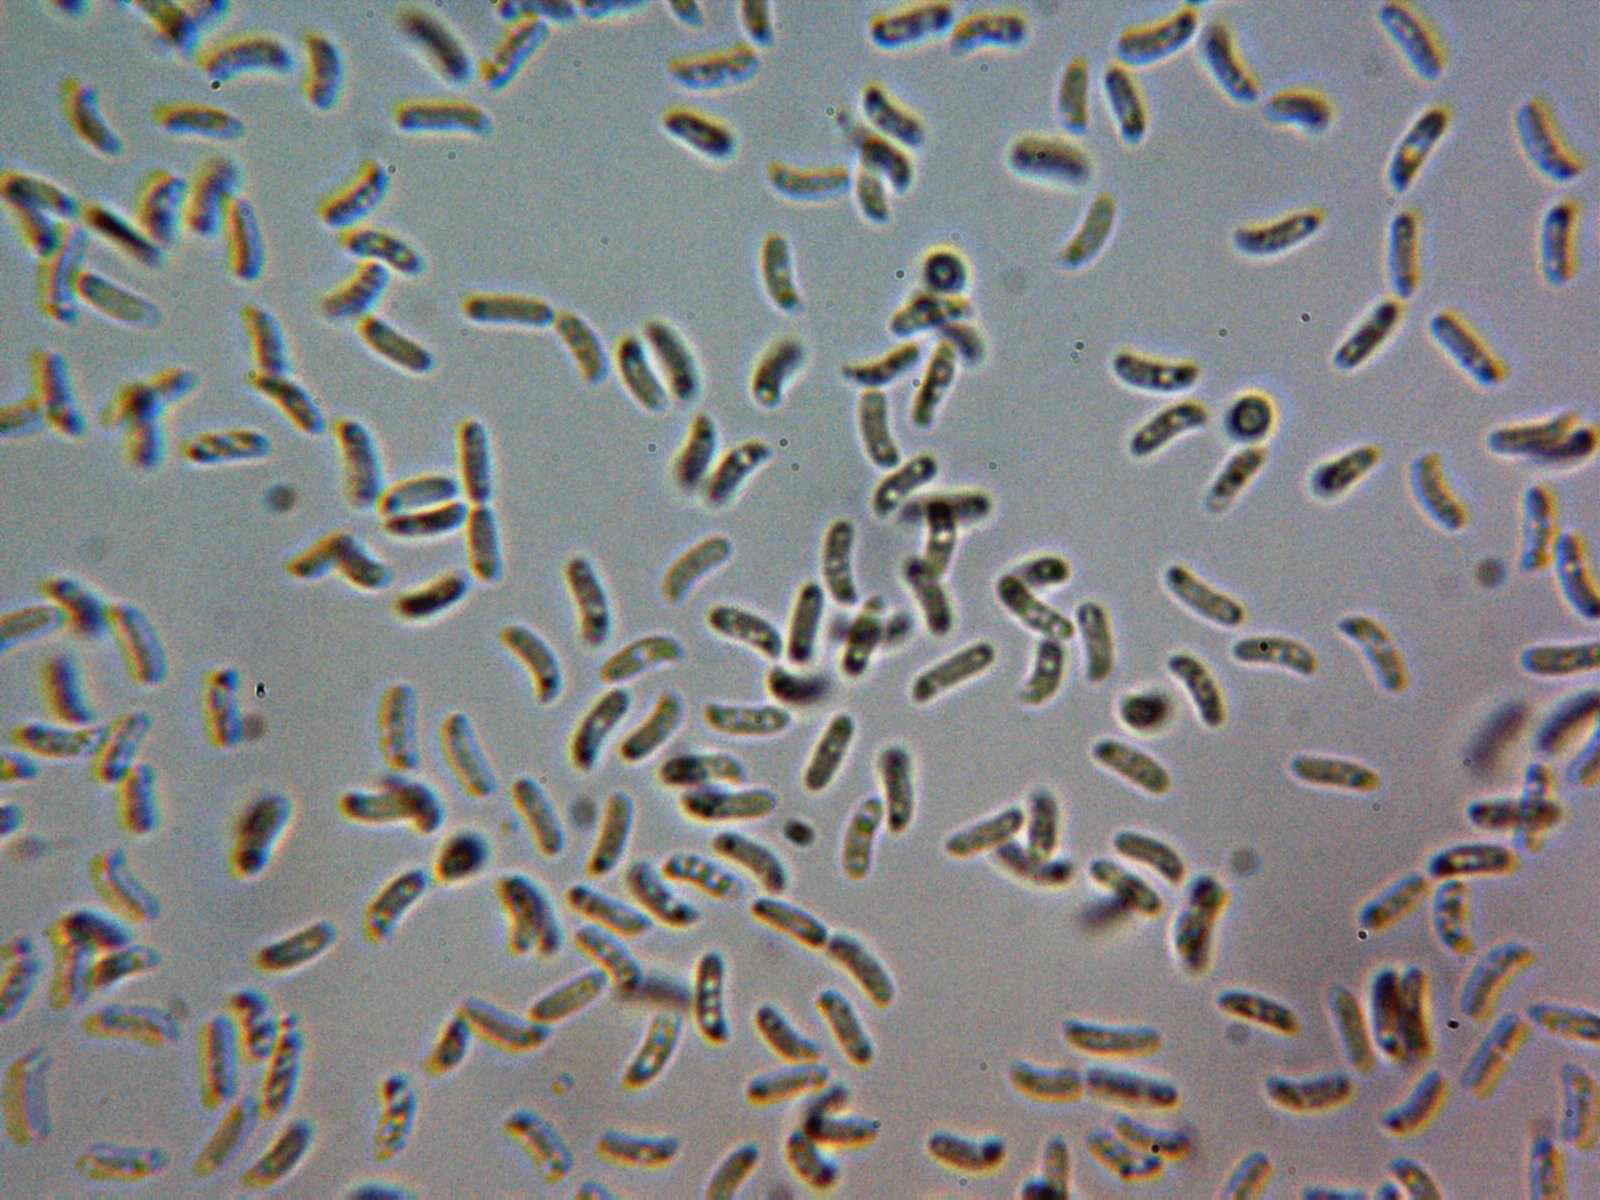

- Foro
- Foros sobre Micología de fungipedia
- Microscopía
- Phlebia subcretacea y más cosas del pasado domingo.
 Phlebia subcretacea y más cosas del pasado domingo.
Phlebia subcretacea y más cosas del pasado domingo.
- Josep Torres
-
 Autor del tema
Autor del tema
- Conectado
- Moderador
-

Menos
Más
- Mensajes: 8746
- Gracias recibidas: 8379
4 años 11 meses antes - 4 años 11 meses antes #105793
por Josep Torres
Hola a tod@s.
Un Corticial que no me había encontrado hasta ahora sobre un tronco tumbado de Pinus sylvestris.
Phlebia subcretacea (Litsch.) MP Cristo. (1960)
Basidioma en el tronco huésped, completamente resupinado, de muy poco grosor (apenas 0,1 a 0,2 mm.) subgelatinoso, de aspecto céreo, de color blanco amarillento con tintes verdosos por la acción de las algas:
Ampliación de su superficie a 40 aumentos:
Hifas subiculares formada solo por hifas generativas (sistema monomítico), hifas con fíbulas y contenido granuloso inmersas en medio de una matriz gelatinosa, hifas de muy poco grosor de tan solo entre 1 a 2 micras, muy irregulares, tortuosas y con algunos ensanchamientos:
Sección a 1000 aumentos:
Basidios tetraspóricos, claviformes, con pedúnculo y esterigmas de hasta 3 micras:
Esporas alantoides, hialinas, de pared fina, con apícula lateral y algunas gotas en su interior:
Las esporas en agua destilada:
Esporas en solución de Rojo Congo diluido:
Esporas en Reactivo de Melzer (inamiloides):
Las medidas de las esporas en agua de:
(5.2) 6 - 6.9 (7.1) × (1.4) 1.6 - 1.9 (2) µm
Q = (3) 3.2 - 4.2 (4.5) ; N = 40
Me = 6.3 × 1.7 µm ; Qe = 3.7
Estas medidas encajan perfectamente con las indicadas en el estudio de Marco Affligio (Aphyllo), donde se indican para la especie unas medidas de (5) 6–7 (8)×1.2–1.7 (2) µm.
Especie muy poco estudiada y con muy pocos documentos donde poder contrastar los resultados, añado una imágen de la microscopía de la Phlebia subcretacea sacada de MycoBank:
Y otra imágen, en este caso sacada de un artículo de ResearchGate:
Unas cuantas imágenes más de lo mucho que se dejó ver este día:
La primera parecía brotar directamente del estiércol, y admito que en un primer momento y a pie de campo me despistó por completo, alguna piña habría debajo ya que se trata sin ninguna duda de la Baeospora myosura
En este nuevo estudio sus pequeñas esporas con unas medidas de:
(3.4) 3.7 - 4.3 (4.4) × (1.9) 1.94 - 2.2 (2.4) µm
Q = (1.6) 1.7 - 2.1 (2.2) ; N = 20
Me = 4 × 2.1 µm ; Qe = 1.9
También y en este caso sí brotando directamente del estiércol, con láminas delicuescentes tenemos el Bolbitius titubans
Sus esporas en este caso con unas medidas de:
(11.1) 11.4 - 12.8 (13.7) × (6.5) 6.8 - 7.8 (8.1) µm
Q = (1.5) 1.6 - 1.8 (1.9) ; N = 30
Me = 12.3 × 7.3 µm ; Qe = 1.7
Sobre estiércol al igual que la anterior el Panaeolus papilionaceus
Sus esporas con unas medidas de:
(14.2) 14.9 - 16.5 (17) × (9.5) 9.8 - 11.1 (11.7) µm
Q = (1.3) 1.4 - 1.59 (1.6) ; N = 20
Me = 15.8 × 10.5 µm ; Qe = 1.5
También un par de Melanoleucas, una con cistidios septados y con cristales en el ápice, muy parecida en el aspecto microscópico con la Melanoleuca substrictipes, esta última con sombrero muy claro, la Melanoleuca exscissa:
Sus esporas con unas medidas de:
(7.5) 7.8 - 8.7 (9.3) × (4.8) 4.9 - 5.4 (5.8) µm
Q = (1.4) 1.5 - 1.7 ; N = 40
Me = 8.2 × 5.1 µm ; Qe = 1.6
Y otra Melanoleuca, de mayor tamaño que la anterior, bajo pinos y de sombreo marrón oscuro, la ausencia de queilocistidios me lleva a la Melanoleuca melaleuca:
Sus esporas con unas medidas en agua de:
(8.4) 8.7 - 9.8 (10.1) × (5.4) 5.5 - 6.3 (6.6) µm
Q = 1.5 - 1.7 (1.8) ; N = 30
Me = 9.3 × 5.9 µm ; Qe = 1.6
Y en Reactivo de Melzer:
(7.9) 8.1 - 9.1 (9.2) × (4.8) 5 - 5.5 (5.7) µm
Q = (1.4) 1.6 - 1.76 (1.8) ; N = 20
Me = 8.6 × 5.2 µm ; Qe = 1.7
Una Mollisia sobre un tronco ya bastante degradado de Crataegus monogyna, típica de Rosáceas, mi segundo estudio a la especie, sin uncínulos en la base de los ascos, la Mollisia rosae:
Sus esporas con unas medidas de:
(6.6) 7.2 - 8.7 (9.2) × (2) 2.4 - 3.1 (3.4) µm
Q = (2.3) 2.4 - 3.3 (4) ; N = 30
Me = 7.9 × 2.8 µm ; Qe = 2.9
Y sobre el mismo sustrato que la anterior una de inconfundible ya solo por su aspecto, con grandes cistidios y pequeñas esporas el Steccherinum fimbriatum:
Sus esporas con unas medidas de:
(3.2) 3.5 - 4 (4.3) × (1.9) 2.2 - 2.5 (2.8) µm
Q = (1.4) 1.5 - 1.8 (2) ; N = 30
Me = 3.8 × 2.4 µm ; Qe = 1.6
Un Mixomiceto muy común que me lo encuentro muy a menudo, la Trichia varia:
Sus esporas con unas medidas de:
(10.8) 11.1 - 12.2 (12.7) × (10.7) 10.9 - 11.8 (12.1) µm
Q = 1 - 1.08 (1.1) ; N = 20
Me = 11.7 × 11.3 µm ; Qe = 1
Un anamorfo, en esta ocasión de la Nectria cinnabarina, la Tubercularia vulgaris:
Y para terminar una imágen (aunque heladas) de las primeras de la temporada, la Marasmius oreades "Senderuelas"
Saludos a tod@s.
Un Corticial que no me había encontrado hasta ahora sobre un tronco tumbado de Pinus sylvestris.
Phlebia subcretacea (Litsch.) MP Cristo. (1960)
Basidioma en el tronco huésped, completamente resupinado, de muy poco grosor (apenas 0,1 a 0,2 mm.) subgelatinoso, de aspecto céreo, de color blanco amarillento con tintes verdosos por la acción de las algas:
Ampliación de su superficie a 40 aumentos:
Hifas subiculares formada solo por hifas generativas (sistema monomítico), hifas con fíbulas y contenido granuloso inmersas en medio de una matriz gelatinosa, hifas de muy poco grosor de tan solo entre 1 a 2 micras, muy irregulares, tortuosas y con algunos ensanchamientos:
Sección a 1000 aumentos:
Basidios tetraspóricos, claviformes, con pedúnculo y esterigmas de hasta 3 micras:
Esporas alantoides, hialinas, de pared fina, con apícula lateral y algunas gotas en su interior:
Las esporas en agua destilada:
Esporas en solución de Rojo Congo diluido:
Esporas en Reactivo de Melzer (inamiloides):
Las medidas de las esporas en agua de:
(5.2) 6 - 6.9 (7.1) × (1.4) 1.6 - 1.9 (2) µm
Q = (3) 3.2 - 4.2 (4.5) ; N = 40
Me = 6.3 × 1.7 µm ; Qe = 3.7
Estas medidas encajan perfectamente con las indicadas en el estudio de Marco Affligio (Aphyllo), donde se indican para la especie unas medidas de (5) 6–7 (8)×1.2–1.7 (2) µm.
Especie muy poco estudiada y con muy pocos documentos donde poder contrastar los resultados, añado una imágen de la microscopía de la Phlebia subcretacea sacada de MycoBank:
Y otra imágen, en este caso sacada de un artículo de ResearchGate:
Unas cuantas imágenes más de lo mucho que se dejó ver este día:
La primera parecía brotar directamente del estiércol, y admito que en un primer momento y a pie de campo me despistó por completo, alguna piña habría debajo ya que se trata sin ninguna duda de la Baeospora myosura
En este nuevo estudio sus pequeñas esporas con unas medidas de:
(3.4) 3.7 - 4.3 (4.4) × (1.9) 1.94 - 2.2 (2.4) µm
Q = (1.6) 1.7 - 2.1 (2.2) ; N = 20
Me = 4 × 2.1 µm ; Qe = 1.9
También y en este caso sí brotando directamente del estiércol, con láminas delicuescentes tenemos el Bolbitius titubans
Sus esporas en este caso con unas medidas de:
(11.1) 11.4 - 12.8 (13.7) × (6.5) 6.8 - 7.8 (8.1) µm
Q = (1.5) 1.6 - 1.8 (1.9) ; N = 30
Me = 12.3 × 7.3 µm ; Qe = 1.7
Sobre estiércol al igual que la anterior el Panaeolus papilionaceus
Sus esporas con unas medidas de:
(14.2) 14.9 - 16.5 (17) × (9.5) 9.8 - 11.1 (11.7) µm
Q = (1.3) 1.4 - 1.59 (1.6) ; N = 20
Me = 15.8 × 10.5 µm ; Qe = 1.5
También un par de Melanoleucas, una con cistidios septados y con cristales en el ápice, muy parecida en el aspecto microscópico con la Melanoleuca substrictipes, esta última con sombrero muy claro, la Melanoleuca exscissa:
Sus esporas con unas medidas de:
(7.5) 7.8 - 8.7 (9.3) × (4.8) 4.9 - 5.4 (5.8) µm
Q = (1.4) 1.5 - 1.7 ; N = 40
Me = 8.2 × 5.1 µm ; Qe = 1.6
Y otra Melanoleuca, de mayor tamaño que la anterior, bajo pinos y de sombreo marrón oscuro, la ausencia de queilocistidios me lleva a la Melanoleuca melaleuca:
Sus esporas con unas medidas en agua de:
(8.4) 8.7 - 9.8 (10.1) × (5.4) 5.5 - 6.3 (6.6) µm
Q = 1.5 - 1.7 (1.8) ; N = 30
Me = 9.3 × 5.9 µm ; Qe = 1.6
Y en Reactivo de Melzer:
(7.9) 8.1 - 9.1 (9.2) × (4.8) 5 - 5.5 (5.7) µm
Q = (1.4) 1.6 - 1.76 (1.8) ; N = 20
Me = 8.6 × 5.2 µm ; Qe = 1.7
Una Mollisia sobre un tronco ya bastante degradado de Crataegus monogyna, típica de Rosáceas, mi segundo estudio a la especie, sin uncínulos en la base de los ascos, la Mollisia rosae:
Sus esporas con unas medidas de:
(6.6) 7.2 - 8.7 (9.2) × (2) 2.4 - 3.1 (3.4) µm
Q = (2.3) 2.4 - 3.3 (4) ; N = 30
Me = 7.9 × 2.8 µm ; Qe = 2.9
Y sobre el mismo sustrato que la anterior una de inconfundible ya solo por su aspecto, con grandes cistidios y pequeñas esporas el Steccherinum fimbriatum:
Sus esporas con unas medidas de:
(3.2) 3.5 - 4 (4.3) × (1.9) 2.2 - 2.5 (2.8) µm
Q = (1.4) 1.5 - 1.8 (2) ; N = 30
Me = 3.8 × 2.4 µm ; Qe = 1.6
Un Mixomiceto muy común que me lo encuentro muy a menudo, la Trichia varia:
Sus esporas con unas medidas de:
(10.8) 11.1 - 12.2 (12.7) × (10.7) 10.9 - 11.8 (12.1) µm
Q = 1 - 1.08 (1.1) ; N = 20
Me = 11.7 × 11.3 µm ; Qe = 1
Un anamorfo, en esta ocasión de la Nectria cinnabarina, la Tubercularia vulgaris:
Y para terminar una imágen (aunque heladas) de las primeras de la temporada, la Marasmius oreades "Senderuelas"
Saludos a tod@s.
Adjuntos:
Última Edición: 4 años 11 meses antes por Josep Torres. Razón: Una falta de ortografía
El siguiente usuario dijo gracias: Juan Andrés Román
Por favor, Identificarse para unirse a la conversación.
- Juan Andrés Román
-

- Fuera de línea
- Spammer
-

Menos
Más
- Mensajes: 2558
- Gracias recibidas: 2756
4 años 11 meses antes #105795
por Juan Andrés Román
Respuesta de Juan Andrés Román sobre el tema Phlebia subcretacea y más cosas del pasado domingo.
El siguiente usuario dijo gracias: Josep Torres
Por favor, Identificarse para unirse a la conversación.
- Josep Torres
-
 Autor del tema
Autor del tema
- Conectado
- Moderador
-

Menos
Más
- Mensajes: 8746
- Gracias recibidas: 8379
4 años 11 meses antes #105796
por Josep Torres
Respuesta de Josep Torres sobre el tema Phlebia subcretacea y más cosas del pasado domingo.
Por favor, Identificarse para unirse a la conversación.
- Foro
- Foros sobre Micología de fungipedia
- Microscopía
- Phlebia subcretacea y más cosas del pasado domingo.
Tiempo de carga de la página: 0.207 segundos

Foro de micología